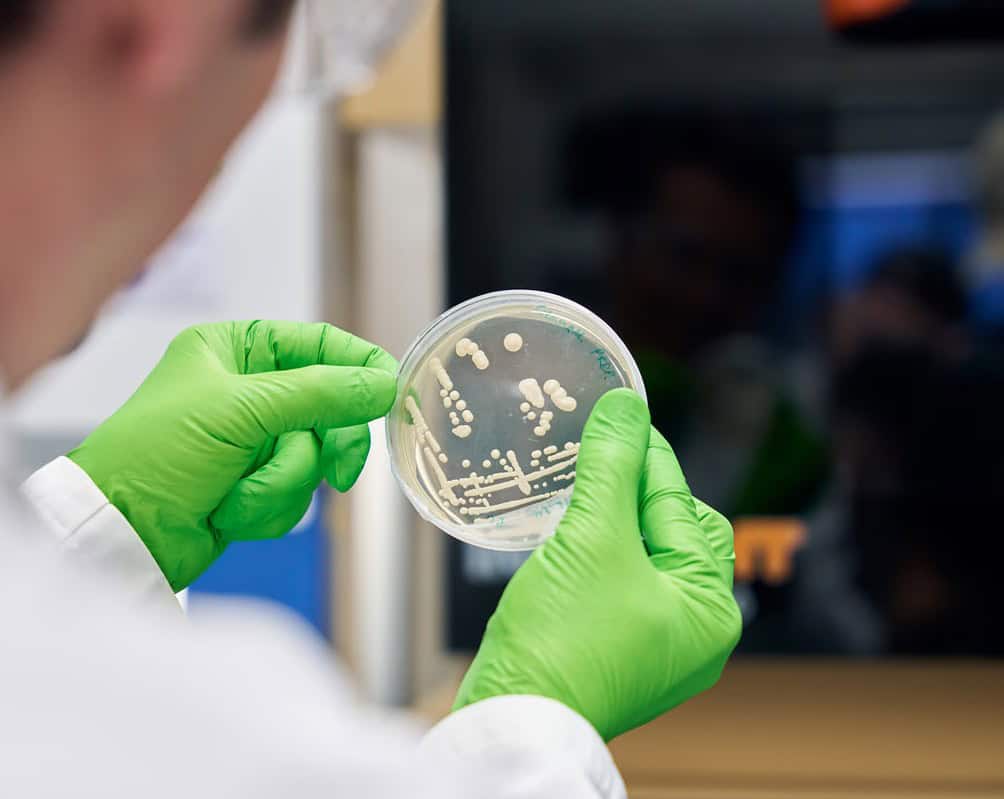
Cosaic

Swiss fermentation startup Cosaic has secured a $6 million seed extension to advance its yeast-based ingredient platform toward commercial launch.
The round was led by dsm-firmenich Ventures, the venture arm of dsm-firmenich, a global ingredients and nutrition company. Additional participants include a Swiss family office, Swiss deeptech investor Kickfund, and existing backers Navus Ventures and Zuercher Kantonalbank.
What Cosaic is building
Cosaic is developing a new category of food ingredients through yeast fermentation. The platform is designed to deliver creaminess, stability, and multifunctional performance within a single ingredient, allowing food and beverage manufacturers to reduce the number of components and additives required in their formulations.
The company positions the ingredient not as a one-to-one replacement for existing inputs, but as a solution to persistent formulation trade-offs between clean label requirements, sensory performance, and cost. Cosaic’s approach targets a practical problem that manufacturers across dairy alternatives, sauces, and other categories continue to face as they work to simplify ingredient decks without compromising product quality.
Use of funds
The capital will support three areas of focus: regulatory submissions, production scale-up, and industrial trials with large client partners. These steps are intended to move Cosaic from the development stage to launch readiness.
“At Cosaic, we are building an ingredient that resolves the trade-offs food companies face every day between clean label, sensory performance, and cost. With strong strategic backing and a capital-efficient scale-up model, we are well positioned to move from development to launch readiness,” stated Tomas Turner, co-founder and CEO.
Strategic backing from Ingredion and dsm-firmenich
The seed extension follows a go-to-market partnership with Ingredion announced in late 2025. That agreement gave Cosaic commercial validation from an established ingredient distributor and opened access to Ingredion’s manufacturing and customer networks.
With dsm-firmenich Ventures now joining as a lead investor alongside Ingredion’s commercial support, Cosaic has secured backing from two of the ingredient industry’s most prominent players at an early stage.
Cosaic is based in Switzerland, a country that has seen sustained activity in the fermentation and precision fermentation space in recent years, alongside growing investment interest from both domestic and international deeptech funds.



